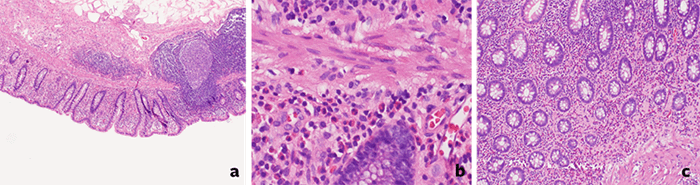

Lower Gastrointestinal Bleeding from the Appendix
A 50-year-old woman presented with symptomatic lower gastrointestinal bleeding from the appendix.
May 17, 2021
Abstract
Background
A 50-year-old woman presented with symptomatic lower gastrointestinal bleeding from the appendix.
Summary
The patient is a 50-year-old morbidly obese woman with bipolar disorder, hypertension, hyperlipidemia, and coronary artery disease complicated by myocardial ischemia necessitating placement of a drug-eluting stent three years prior and maintained on aspirin and clopidogrel. She underwent gastric bypass surgery and was discharged to home on postoperative day one. She returned to the hospital 34 days later with symptoms consistent with gastrointestinal bleeding. Upper endoscopy revealed a small marginal ulcer but did not have any high-risk stigmata. A lower endoscopy was performed and found the source of gastrointestinal bleeding to be the appendix. Laparoscopic appendectomy was performed, and she had a resolution of her symptoms.
Conclusion
Lower gastrointestinal bleeding is a common cause for endoscopic and surgical intervention. In difficult diagnostic situations or in those on dual antiplatelet therapy, the appendix should be considered as a possible source of bleeding. The recommended treatment for such is an appendectomy if there is no associated regional neoplasia or vascular pathology.
Key Words
appendix; appendiceal; gastrointestinal; bleed; bleeding; hemorrhage
Case Description
Gastrointestinal (GI) bleeding is not a rare occurrence in today’s era of medicine. Sources of lower GI bleeding (LGIB) predominantly consist of arteriovenous malformations, hemorrhoids, diverticulosis, GI inflammatory processes, or neoplasms.1 Fifteen percent of severe hematochezia is due to an upper GI source, while 85 percent is due to a lower GI source.2-6 However, documentation of LGIB secondary to appendiceal etiology is uncommon as documented in the few existing literature reports—just 26 cases. Standard treatment of appendiceal bleeding is surgical with reports of appendectomy, ileocecectomy, partial cecectomy, or hemicolectomy.2,3
We report a case of a 50-year-old female with an extensive past medical history significant for hypertension, bipolar disorder, hyperlipidemia, coronary artery disease complicated by myocardial infarction that required a drug-eluting stent placement three years prior and was placed on dual antiplatelet therapy of 81 mg of aspirin and 75 mg of clopidogrel. She was morbidly obese and had been unable to lose weight via conventional methods for her entire adult life. She underwent the preoperative assessment associated with Saint Francis Medical Center bariatric program, including group classes, discussions with dieticians, and psychological evaluation. She was cleared for surgery, and her dual antiplatelet therapy (DAPT) was held three days pre-operatively with the plan to resume both seven days postoperatively. Preoperative laboratory evaluation demonstrated no anemia. A laparoscopic Roux-en-Y gastric bypass was performed in the usual manner without complication. On postoperative day (POD) one, her Foley catheter was removed, and her diet was advanced to low-volume clear liquids. She progressed well and was discharged home on the POD 1 with pain well-controlled and was to resume DAPT on POD seven. She was seen in the office on POD 14 and had no complaints. She then presented to the hospital on POD 35 with reports of melena and bright red blood per rectum (BRBPR) accompanied by lightheadedness. A digital rectal exam demonstrated melena but no bright red blood. Hemoccult testing was positive. Her hemoglobin on presentation was stable with less than 1 gram/decaliter (g/dL) drop since discharge. However, on repeat the next day, her hemoglobin dropped 3 g/dL. Though she had no symptoms of epigastric pain or burning, concern for anastomotic bleed was great due to her recent operation. She was scheduled for an upper endoscopy, which showed a mild anastomotic ulcer without high-risk stigmata. This was thought unlikely to have resulted in her acute blood loss anemia and current clinical condition. The decision was made to perform a colonoscopy.
The patient was kept inpatient and received a bowel prep. On colonoscopy, clot and fresh blood were encountered in the ascending colon; the remainder of the distal colon was within normal limits. The cecum was reached, and the location was confirmed via anatomic landmarks. A noteworthy finding was blood emanating from the appendiceal orifice (Figure 1).
Figure 1. Appendiceal orifice seen with associated endoluminal hemorrhage as seen on colonoscopic evaluation

This was confirmed as new bleeding based on copious irrigation and persistent fresh bleeding from the appendiceal orifice. There was some concern for significant neoplastic or vascular pathology, so a computed tomography (CT) scan was performed to evaluate the appendix, which was unremarkable. However, given that the patient had visible bleeding from the appendiceal orifice on colonoscopy and her need to resume her antiplatelet therapy, a laparoscopic appendectomy was planned for the next day. This was performed without incident. The intraoperative findings appeared to be within normal limits (Figure 2). The appendix was incised, and there was no gross evidence of ulceration or stigmata of recent hemorrhage (Figure 3).
Figure 2. Intraoperative view of appendix without signs of external hemorrhage.

Figure 3. Gross appendix without evidence of mucosal hemorrhage or ulceration
After subsequent appendectomy, histologic evaluation revealed increased eosinophils in the mucosa and superficial submucosa without any evidence of vascular malformation (Figure 4). This was a normal pathologic finding.
Figure 4. Pathologic examination of resected appendix. A) 4x, H&E. Normal germinal center. B) Figure 4B: 40x, H&E blood vessels. No evidence of angiodysplasia. C) 10x, H&E. Increased eosinophils.
Discussion
The differential diagnosis for lower GI bleeding comprises a long list that includes arteriovenous malformations, inflammatory bowel disease, diverticulosis, carcinoma, and ischemic disease. This can be further delineated by the specific site of the lower GI tract where the bleeding is happening and underlines the importance of the diagnostic workup for LGIB. Endoscopy is an important step in the diagnosis. There have been reports of endoscopic clipping of the appendix to provide some tamponade effect with success in the setting of known angiodysplastic disease.5 However, given the natural history of progression for the development of appendicitis, this was seen to be contraindicated. Angiographic interventions were deemed higher risk for complication in an otherwise healthy patient as this can result in full-thickness infarction and bowel wall perforation.6
The specimen should be opened and evaluated on the back table by the surgeon prior to being sent for pathologic evaluation. The colonic eosinophils seen in the lamina propria on pathologic evaluation, in this case, are not considered abnormal and can represent infectious or drug-induced etiologies, making it a nonspecific finding. Pathologic abnormality occurs if there is an epithelial extension, aggregation, or extensive degranulation.4 In our patient, there was no such finding. Histologic evaluation was notable for increased eosinophils predominantly in the mucosa and superficial submucosa with minimal involvement of crypt epithelium; overall, crypt architecture was also well preserved.
The lack of findings on pathology that explains the appendiceal bleeding was unsatisfying, but symptomatic relief with appendectomy has led us to be skeptically optimistic for this patient’s effective treatment. Spontaneous GI bleeding is a known complication of antiplatelet therapy, and this appears to be the most likely cause in her case based on the available data. In summary, the appendix should be considered as a possible source of bleeding in patients with LGIB on DAPT.
Conclusion
Acute lower GI bleeding of the appendix is an undoubtedly rare occurrence as suggested by the few literature reports. It should be considered in patients with difficult-to-diagnose LGIB, especially those on DAPT or some of the novel oral anticoagulation medications.
Lessons Learned
GIB after GI surgery should always be suspected to be bleeding at the surgical site until proven otherwise. When the most likely sources are excluded, the normal workup for GIB should be employed. Be prepared to be surprised at the source of bleeding and the effectiveness of simple interventions to cure the patient.
Authors
Nitz JA; Medina MG; AlAmeer ES; Rossi TR
Author Affiliation
University of Illinois College of Medicine at Peoria, Department of Surgery, Peoria, IL 61603
Corresponding Author
Jonathan Nitz, MD
624 NE Glen Oak, Room 2670
Peoria, IL 61603
Phone: (502) 320-4248
E-mail: jonathan.nitz@gmail.com
Disclosure Statement
The authors have no conflicts of interest to disclose.
Acknowledgments
The authors would like to thank Melissa Hudak, MLIS, manager of OSF SFMC Library and Resource Center, for assistance with the initial literature review; Hamid Mahmood Zia, MD, for determining the initial pathological diagnosis, providing pathology images used, and for his time in discussing pertinent pathological features and significance.
References
- Zuccaro, Gregory. “Epidemiology of lower gastrointestinal bleeding.” Best practice & research. Clinical gastroenterology vol. 22,2 (2008): 225-32. doi:10.1016/j.bpg.2007.10.009 Yamazaki, Kimiyasu et al. “Successful laparoscopic treatment of hemorrhage from the appendix with phlegmonous acute appendicitis: a case report and review of the literature.” Gastrointestinal endoscopy vol. 63,6 (2006): 877-80. doi:10.1016/j.gie.2006.01.002
- Konno, Youkou et al. “A therapeutic barium enema is a practical option to control bleeding from the appendix.” BMC gastroenterology vol. 13 152. 25 Oct. 2013, doi:10.1186/1471-230X-13-152
- Yantiss, Rhonda K. “Eosinophils in the GI tract: how many is too many and what do they mean?.” Modern pathology : an official journal of the United States and Canadian Academy of Pathology, Inc vol. 28 Suppl 1 (2015): S7-21. doi:10.1038/modpathol.2014.132
- Park, Il et al. “Colonoscopic clipping as a treatment for appendiceal bleeding.” Gut and liver vol. 4,3 (2010): 411-4. doi:10.5009/gnl.2010.4.3.411
- Gerlock, A J Jr et al. “Infarction after embolization of the ileocolic artery.” Cardiovascular and interventional radiology vol. 4,3 (1981): 202-5. doi:10.1007/BF02552424
- Ghassemi, Kevin A, and Dennis M Jensen. “Lower GI bleeding: epidemiology and management.” Current gastroenterology reports vol. 15,7 (2013): 333. doi:10.1007/s11894-013-0333-5